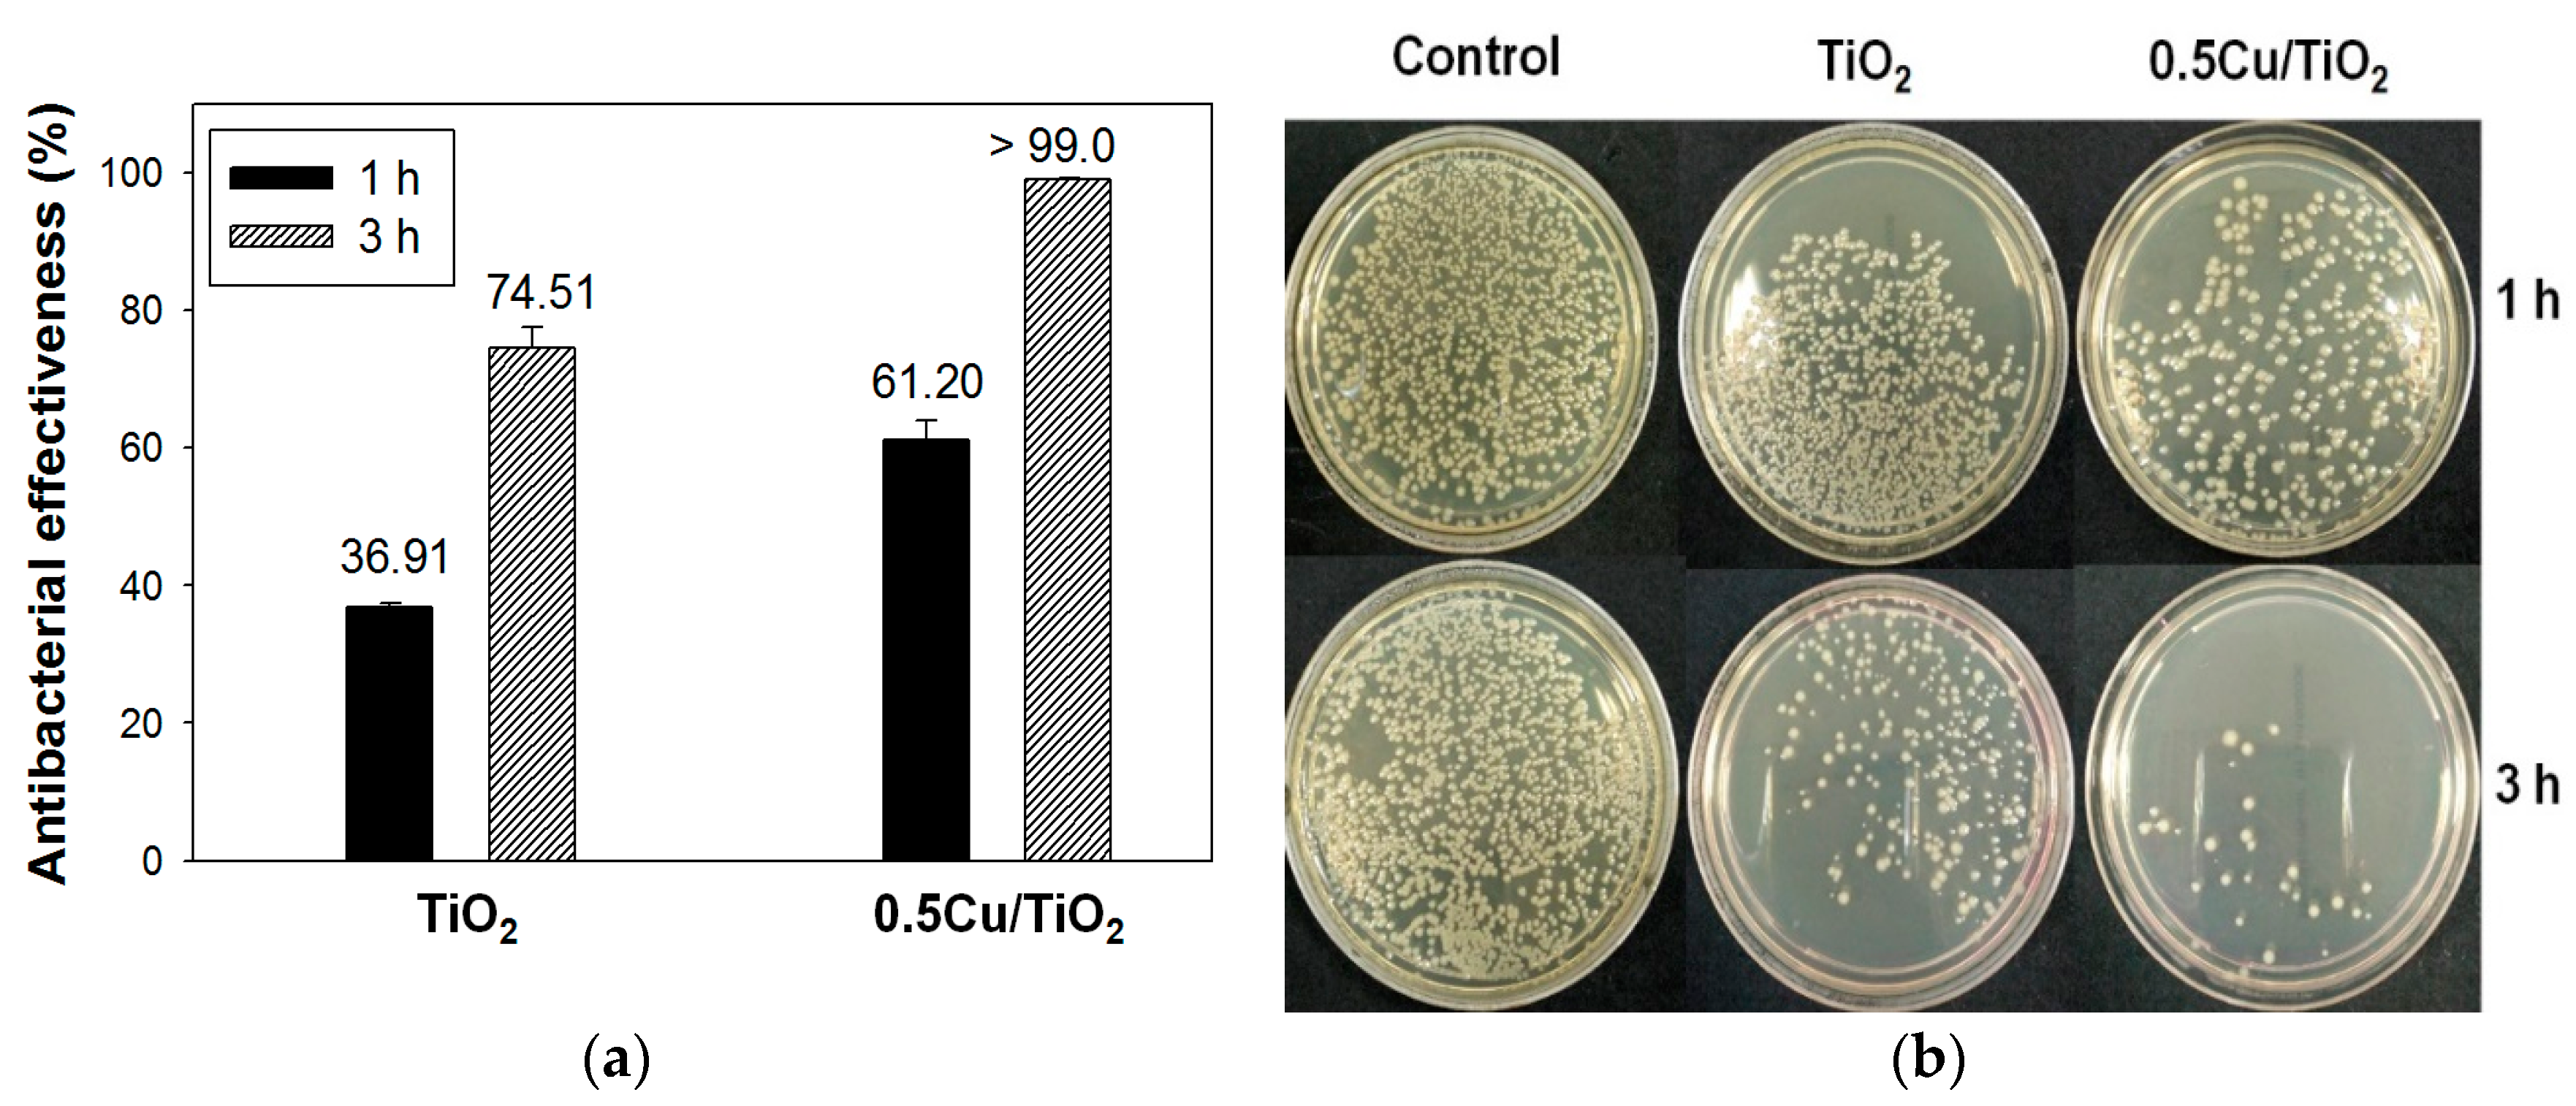
Catalysts 08 00352 g006 Catalysts 08 00352 g006

Photocatalytic Antibacterial Effectiveness of Cu-Doped TiO2 Thin Film Prepared via the Peroxo Sol-Gel Method
Abstract
1. Introduction
2. Results and Discussion
2.1. Characteristic of Cu-Doped TiO2 Particles
2.2. Characterization of Cu-Doped TiO2 Thin Film
2.3. Photocatalytic Degradation of MB Aqueous Solution
2.4. Photocatalytic Antibacterial Effectiveness of Cu-doped TiO2 Thin Film
3. Materials and Methods
3.1. Materials
3.2. Preparation of TiO2 and Cu-Doped TiO2 Sol
3.3. Preparation of Films
3.4. Characterization of Cu-Doped TiO2 Particles and Thin Films
3.5. Photocatalytic Degradation of MB Aqueous Solution
3.6. Study of Antibacterial Activity
4. Conclusions
Author Contributions
Funding
Acknowledgments
Conflicts of Interest
References
- Vinodgopal, K.; Wynkoop, D.; Kamat, P. Environmental photochemistry on semiconductor surfaces: Photosensitized degradation of a textile azo dye, acid orange 7, on TiO2 particles using visible light. Environ. Sci. Technol. 1996, 30, 1660–1666. [Google Scholar] [CrossRef]
- Mohamed, M.; Al-Esaimi, M. Characterization, adsorption and photocatalytic activity of vanadium-doped TiO2 and sulfated TiO2 (rutile) catalysts: Degradation of methylene blue dye. J. Mol. Catal. A Chem. 2006, 255, 53–61. [Google Scholar] [CrossRef]
- Moongraksathum, B.; Chen, Y.W. CeO2–TiO2 mixed oxide thin films with enhanced photocatalytic degradation of organic pollutants. J. Sol-Gel Sci. Technol. 2017, 82, 772–782. [Google Scholar] [CrossRef]
- Chong, M.; Jin, B.; Chow, C.; Saint, C. Recent developments in photocatalytic water treatment technology: A. review. Water Res. 2010, 44, 2997–3027. [Google Scholar] [CrossRef] [PubMed]
- Fujishima, A.; Zhang, X.; Tryk, D. TiO2 photocatalysis and related surface phenomena. Surf. Sci. Rep. 2008, 63, 515–582. [Google Scholar] [CrossRef]
- Guan, K. Relationship between photocatalytic activity, hydrophilicity and self-cleaning effect of TiO2/SiO2 films. Surf. Coat. Technol. 2005, 191, 155–160. [Google Scholar] [CrossRef]
- Moongraksathum, B.; Chen, Y.W. Preparation and characterization of SiO2–TiO2 neutral sol by peroxo sol-gel method and its application on photocatalytic degradation. J. Sol-Gel Sci. Technol. 2016, 77, 288–297. [Google Scholar] [CrossRef]
- Sakai, N.; Fujishima, A.; Watanabe, T.; Hashimoto, K. Quantitative evaluation of the photoinduced hydrophilic conversion properties of TiO2 thin film surfaces by the reciprocal of contact angle. J. Phys. Chem. B 2003, 107, 1028–1035. [Google Scholar] [CrossRef]
- Watanabe, T.; Fukayama, S.; Miyauchi, M.; Fujishima, A.; Hashimoto, K. Photocatalytic activity and photo-induced wettability conversion of TiO2 thin film prepared by sol-gel process on a soda-lime glass. J. Sol-Gel Sci. Technol. 2000, 19, 71–76. [Google Scholar] [CrossRef]
- Sunada, K.; Watanabe, T.; Hashimoto, K. Bactericidal activity of copper-deposited TiO2 thin film under weak UV light illumination. Environ. Sci. Technol. 2003, 37, 4785–4789. [Google Scholar] [CrossRef] [PubMed]
- Pelaez, M.; Nolan, N.; Pillai, S.; Seery, M.; Falaras, P.; Kontos, A.; Dunlop, P.; Hamilton, J.; Byrne, J.; O’Shea, K.; et al. A review on the visible light active titanium dioxide photocatalysts for environmental applications. Appl. Catal. B 2012, 125, 331–349. [Google Scholar] [CrossRef]
- Moongraksathum, B.; Chen, Y.W. Anatase TiO2 co-doped with silver and ceria for antibacterial application. Catal. Today 2018, 310, 68–74. [Google Scholar] [CrossRef]
- Verdier, T.; Coutand, M.; Bertron, A.; Roques, C. Antibacterial activity of TiO2 photocatalyst alone or in coatings on E. coli: The influence of methodological aspects. Coatings 2014, 4, 670–686. [Google Scholar] [CrossRef]
- Maness, P.; Smolinski, S.; Blake, D.M.; Huang, Z.; Wolfrum, E.J.; Jacoby, W.A. Bactericidal activity of photocatalytic TiO2 reaction: Toward an understanding of its killing mechanism. Appl. Environ. Microb. 1999, 65, 4094–4098. [Google Scholar]
- Castro, C.; Sanjines, R.; Pulgarin, C.; Osorio, P.; Giraldo, S.A.; Kiwi, J. Structure-reactivity relations of the Cu-cotton sputtered layers during E. coli inactivation in the dark and under light. J. Photochem. Photobiol. A 2010, 216, 295–302. [Google Scholar] [CrossRef]
- Richardson, S.D.; Thruston, A.D.; Collette, T.W.; Ireland, J.C. Identification of TiO2/UV disinfection byproducts in drinking water. Environ. Sci. Technol. 1996, 30, 3327–3334. [Google Scholar] [CrossRef]
- Leyland, N.; Podporska-Carroll, J.; Browne, J.; Hinder, S.; Quilty, B.; Pillai, S. Highly Efficient F, Cu doped TiO2 anti-bacterial visible light active photocatalytic coatings to combat hospital-acquired infections. Sci. Rep. 2016, 6, 24770. [Google Scholar] [CrossRef] [PubMed]
- Litter, M. Heterogeneous photocatalysis Transition metal ions in photocatalytic systems. Appl. Catal. B Environ. 1999, 23, 89–114. [Google Scholar] [CrossRef]
- Espirito Santo, C.; Quaranta, D.; Grass, G. Antimicrobial metallic copper surfaces kill Staphylococcus haemolyticus via membrane damage. MicrobiologyOpen 2012, 1, 46–52. [Google Scholar] [CrossRef] [PubMed]
- Grass, G.; Rensing, C.; Solioz, M. Metallic copper as an antimicrobial surface. Appl. Environ. Microbiol. 2011, 77, 1541–1546. [Google Scholar] [CrossRef] [PubMed]
- Rtimi, S.; Pulgarin, C.; Kiwi, J. Recent developments in accelerated antibacterial inactivation on 2D Cu-Titania surfaces under indoor visible light. Coatings 2017, 7, 20. [Google Scholar] [CrossRef]
- Sasirekha, N.; Rajesh, B.; Chen, Y.W. Synthesis of TiO2 sol in a neutral solution using TiCl4 as a precursor and H2O2 as an oxidizing agent. Thin Solid Films 2009, 518, 43–48. [Google Scholar] [CrossRef]
- Chen, Y.W.; Chang, J.Y.; Moongraksathum, B. Preparation of vanadium–doped titanium dioxide neutral sol and its photocatalytic applications under UV light irradiation. J. Taiwan Inst. Chem. Eng. 2015, 52, 140–146. [Google Scholar] [CrossRef]
- Moongraksathum, B.; Hsu, P.T.; Chen, Y.W. Photocatalytic activity of ascorbic acid-modified TiO2 sol prepared by the peroxo sol-gel method. J. Sol-Gel Sci. Technol. 2016, 78, 647–659. [Google Scholar] [CrossRef]
- Moongraksathum, B.; Chien, M.Y.; Chen, Y.W. Antiviral and antibacterial effects of silver-doped TiO2 prepared by the peroxo sol–gel method. J. Nanosci. Nanotechnol. Accepted.
- Monshi, A.; Foroughi, M.R.; Monshi, M.R. Modified Scherrer equation to estimate more accurately nano-crystallite size using XRD. World J. Nano Sci. Eng. 2012, 2, 154–160. [Google Scholar] [CrossRef]
- Alexander, L.; Klug, H.P. Determination of crystallite size with the X–ray spectrometer. J. Appl. Phys. 1950, 21, 137–142. [Google Scholar] [CrossRef]
- Dake, L.S.; Lad, R.J. Electronic and chemical interactions at aluminum/TiO2 (110) interfaces. Surf. Sci. 1993, 289, 297–306. [Google Scholar] [CrossRef]
- Su, J.; Li, Z.; Zhang, Y.; Wei, Y.; Wang, X. N-Doped and Cu-doped TiO2-B nanowires with enhanced photoelectrochemical activity. RSC Adv. 2016, 6, 16177–16182. [Google Scholar] [CrossRef]
- Wang, S.; Meng, K.; Zhao, L.; Jiang, Q.; Lian, J. Superhydrophilic Cu-doped TiO2 thin film for solar-driven photocatalysis. Ceram. Int. 2014, 40, 5107–5110. [Google Scholar] [CrossRef]
- Eshaghi, A.; Eshaghi, A. Preparation and hydrophilicity of TiO2 sol–gel derived nanocomposite films modified with copper loaded TiO2 nanoparticles. Mater. Res. Bull. 2011, 46, 2342–2345. [Google Scholar] [CrossRef]
- Xu, Y.; Li, J.A.; Yao, L.F.; Li, L.H.; Yang, P.; Huang, N. Preparation and characterization of Cu-doped TiO2 thin films and effects on platelets adhesion. Surf. Coat. Technol. 2015, 261, 436–441. [Google Scholar] [CrossRef]
- Behnajady, M.; Shokri, M.; Taba, H.; Modirshahla, N. Photocatalytic activity of Cu doped TiO2 nanoparticles and comparison of two main doping procedures. Micro Nano Lett. 2013, 8, 345–348. [Google Scholar] [CrossRef]
- Moniz, S.J.A.; Tang, J. Charge transfer and photocatalytic activity in CuO/TiO2 nanoparticle heterojunctions synthesised through a rapid, one-pot, microwave solvothermal route. ChemCatChem 2015, 7, 1659–1667. [Google Scholar] [CrossRef]
- Janczarek, M.; Kowalska, E. On the origin of enhanced photocatalytic activity of copper-modified titania in the oxidative reaction systems. Catalysts 2017, 7, 317. [Google Scholar] [CrossRef]
- Applerot, G.; Lellouche, J.; Lipovsky, A.; Nitzan, Y.; Lubart, R.; Gedanken, A.; Banin, E. Understanding the antibacterial mechanism of CuO nanoparticles: Revealing the route of induced oxidative stress. Small 2012, 8, 3326–3337. [Google Scholar] [CrossRef] [PubMed]

| Sample | Weight Ratio of Cu:TiO2 | Crystallite Size (nm) |
|---|---|---|
| TiO2 | 0:100 | 14.96 |
| 0.1Cu/TiO2 | 0.1:100 | 9.12 |
| 0.3Cu/TiO2 | 0.3:100 | 9.40 |
| 0.5Cu/TiO2 | 0.5:100 | 9.21 |
| 0.7Cu/TiO2 | 0.7:100 | 9.60 |
| 1Cu/TiO2 | 1:100 | 10.16 |
| Sample | Lattice O2− | Ti-OH | ||
|---|---|---|---|---|
| BE (eV) | Fraction (%) | BE (eV) | Fraction (%) | |
| TiO2 | 530.7 | 81.48 | 531.7 | 18.52 |
| 0.5Cu/TiO2 | 530.6 | 73.72 | 531.6 | 26.28 |
| Samples | Rate Constant (k, h−1) | |
|---|---|---|
| Under UV light | Under Visible Light | |
| TiO2 | 0.449 | 0.070 |
| 0.1Cu/TiO2 | 0.687 | 0.066 |
| 0.3Cu/TiO2 | 0.546 | 0.098 |
| 0.5Cu/TiO2 | 0.737 | 0.160 |
| 0.7Cu/TiO2 | 0.524 | 0.146 |
| 1Cu/TiO2 | 0.317 | 0.076 |
© 2018 by the authors. Licensee MDPI, Basel, Switzerland. This article is an open access article distributed under the terms and conditions of the Creative Commons Attribution (CC BY) license (http://creativecommons.org/licenses/by/4.0/).
Share and Cite
Moongraksathum, B.; Shang, J.-Y.; Chen, Y.-W. Photocatalytic Antibacterial Effectiveness of Cu-Doped TiO2 Thin Film Prepared via the Peroxo Sol-Gel Method. Catalysts 2018, 8, 352. https://doi.org/10.3390/catal8090352
Moongraksathum B, Shang J-Y, Chen Y-W. Photocatalytic Antibacterial Effectiveness of Cu-Doped TiO2 Thin Film Prepared via the Peroxo Sol-Gel Method. Catalysts. 2018; 8(9):352. https://doi.org/10.3390/catal8090352
Chicago/Turabian StyleMoongraksathum, Benjawan, Jun-Ya Shang, and Yu-Wen Chen. 2018. "Photocatalytic Antibacterial Effectiveness of Cu-Doped TiO2 Thin Film Prepared via the Peroxo Sol-Gel Method" Catalysts 8, no. 9: 352. https://doi.org/10.3390/catal8090352
APA StyleMoongraksathum, B., Shang, J.-Y., & Chen, Y.-W. (2018). Photocatalytic Antibacterial Effectiveness of Cu-Doped TiO2 Thin Film Prepared via the Peroxo Sol-Gel Method. Catalysts, 8(9), 352. https://doi.org/10.3390/catal8090352

